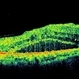

-
 By Neha Goel, MS DNB FRCS (Glasg)
By Neha Goel, MS DNB FRCS (Glasg)
Eye7 Chaudhary Eye Centre - Uploaded on Aug 31, 2014.
- Last modified by Caroline Bozell on Sep 2, 2014.
- Rating
- Appears in
- Diabetic retinopathy
- Condition/keywords
- proliferative diabetic retinopathy (PDR), fibrovascular proliferation, ischaemic diabetic maculopathy
- Photographer
- Neha Goel
- Imaging device
-
Fundus camera
Zeiss Visucam - Description
- Fundus photograph of the left eye.


 Initializing download.
Initializing download.---thumb.jpg/image-square;max$79,0.ImageHandler)